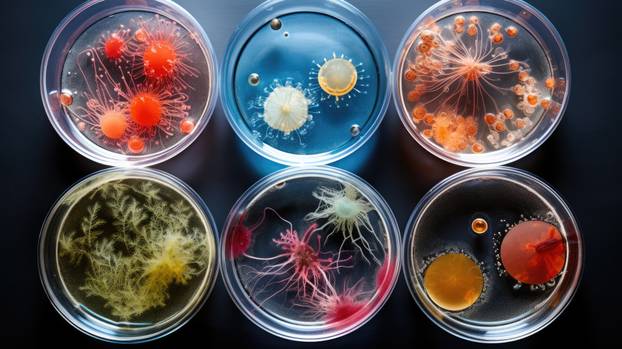
Background with mixed bacteria colonies, fungi or microbes in va

Od mediteranskog maslinovog ulja do skandinavske ribe, istraživači integriraju digitalne tehnologije u ključne europske prehrambene industrije kako bi suzbili krivotvorene proizvode
Lifestyle
Komentari 0
Od mediteranskog maslinovog ulja do skandinavske ribe, istraživači integriraju digitalne tehnologije u ključne europske prehrambene industrije kako bi suzbili krivotvorene proizvode
S valovitih brežuljaka Umbrije pruža se idiličan pogled na neke od najljepših i najstarijih talijanskih maslinika. Sada ti drevni voćnjaci pomažu u borbi protiv prijevara povezanih s hranom, problema zbog kojeg EU gubi između 8 i 12 milijardi eura svake godine.
POGLEDAJTE VIDEO:
Pokretanje videa...
 01:44
01:44
Umbrijski proizvođači maslinovog ulja pružaju skupini istraživača i stručnjaka za hranu koje financira EU uzorke svojeg proslavljenog ekstra djevičanskog maslinovog ulja kako bi testirali nove prijenosne metode provjere autentičnosti temeljene na DNK-u koje će poboljšati zaštitu njihove industrije od prijevara i obmana.
-Testiranje DNK-a stvara transparentan proizvod - rekao je dr. Stelios Arhondakis, izvršni direktor tvrtke BioCoS, grčke biotehnološke tvrtke sa sjedištem na Kreti.
Ekstra djevičansko maslinovo ulje proizvod je visoke vrijednosti, što ga čini unosnom metom za prevarante. Krivotvorenje može uključivati razrjeđivanje boca uljima niže kvalitete, kao što su druge, jeftinije vrste maslinovog ulja ili čak biljno ulje, ili pogrešno označavanje sorte ili zemljopisnog podrijetla proizvoda.

BioCoS je specijaliziran za rješenja sljedivosti temeljena na DNK-u s ciljem borbe protiv prijevara povezanih s hranom i poboljšanja transparentnosti u poljoprivredno-prehrambenom sektoru. - Ako točno znate što se nalazi u boci, ne možete dodati ili umiješati ništa drugo - rekao je Arhondakis.
Njihov rad dio je trogodišnje istraživačke inicijative pod nazivom WATSON koju financira EU, a koja okuplja 47 partnera za istraživanje i tehnološki razvoj iz 20 zemalja EU-a i zemalja koje nisu članice EU-a.
Arhondakis objašnjava da će njihova metoda temeljena na DNK-u nadopuniti druge postojeće testove, poboljšati sljedivost i pružiti lako dostupan novi alat za provjeru autentičnosti DNK-a za proizvođače širokog spektra prehrambenih proizvoda. - Naš je cilj stvoriti pristupačan, brz i precizan sustav testiranja DNK-a na licu mjesta koji se može upotrebljavati za dobivanje brzih rezultata u bilo kojem trenutku opskrbnog lanca, minimizirajući potrebu za laboratorijskom opremom i posebnom stručnošću - rekao je.
Testom DNK-a utvrdit će se genetski profil prehrambenog proizvoda. Te će se informacije zatim pohraniti s pomoću tehnologije lanca blokova otporne na neovlaštene izmjene, čime će se učinkovito stvoriti digitalna knjiga zapisa. Te će evidencije biti dostupne dionicima uključenima u proizvodnju, prijevoz i maloprodaju ciljnih prehrambenih proizvoda, a prema potrebi i tijelima nadležnima za hranu.
Osim maslinovog ulja, istraživački tim projekta WATSON provodi pet pilot istraživanja u europskim prehrambenim industrijama koje su najviše pogođene prijevarama: med (Španjolska), meso (Njemačka), mliječni proizvodi i žitarice (Finska), bijela riba (Norveška) i vino (Portugal).
Dr. Dimitrios Argyropoulos voditelj je Digitalnog tehnološkog laboratorija Škole za biosustave i prehrambeno inženjerstvo Sveučilišta u Dublinu u Irskoj i odgovoran je za koordinaciju istraživanja koje provodi tim projekta WATSON. Njegovo se istraživanje usredotočuje na održive poljoprivredno-prehrambene vrijednosne lance, a posebno ga zanima primjena Interneta stvari (IoT), senzorskih tehnologija i umjetne inteligencije u proizvodnji hrane.
To bi moglo uključivati senzore temeljene na DNK-u ili specijalizirano snimanje radi utvrđivanja sastojaka ili uređaje IoT koji povezuju prehrambene proizvode s internetom kako bi automatski pratili njihovo podrijetlo, kretanje, lokaciju pa čak i temperaturu skladištenja.

- Usredotočeni smo na alate koji su jeftini, gdje je to moguće, i prenosivi u cijelom lancu opskrbe hranom - rekao je dr. Dimitrios Argyropoulos.
U Portugalu je ključni prioritet učiniti senzore i tehnologiju IoT dostupnima proizvođačima vina. Cilj je biti u mogućnosti pratiti grožđe od njegove točne parcele u vinogradu sve do procesa berbe i transporta do konačnog proizvodnog mjesta. Poboljšanje sljedivosti snažan je način suzbijanja prijevara s hranom, pomažući u zatvaranju rupa u lancu opskrbe koje bi organizirani kriminal inače mogao iskoristiti.
Podaci o praćenju lanca vrijednosti zajedno s umjetnom inteligencijom pružit će sustav ranog upozoravanja koji može označiti sve nepravilnosti i pomoći u otkrivanju prijevarnih aktivnosti u stvarnom vremenu i na samom mjestu događaja, objasnio je dr. Pedro Miguel Carvalho, viši istraživač na Institutu za sustave i računalno inženjerstvo, tehnologiju i znanost u Portu, Portugal.
- Primjerice, ako kamion koji prevozi grožđe krene neočekivanim putem ili napravi neuobičajeno zaustavljanje, to bi mogao biti znak pokušaja presretanja grožđa - rekao je.

Prema Carvalhu, posao koji obavljaju istraživači projekta WATSON ključan je s obzirom na razmjere vinskih prijevara u EU-u. Zbog prijevara povezanih s vinom redovni vinski sektor EU-a gubi oko 1,3 milijarde eura godišnje, što je oko 3 % ukupne prodajne vrijednosti. Više od milijun litara krivotvorenih alkoholnih pića, uglavnom vina, zaplijenjeno je diljem Europe 2020. godine i više od 1,7 milijuna 2021. godine u ciljanim akcijama koje je vodio Europski ured za borbu protiv prijevara u sklopu zajedničkih operacija Europola i Interpola.
Cilj brojnih prototipnih tehnologija u razvoju je da potrošači mogu s pomoću pametnog telefona skenirati oznake i pristupiti biografskim detaljima proizvoda predstavljenog u obliku „putovnice za hranu”.
Nadamo se da će do završetka rada istraživača 2026. godine nove tehnologije biti usvojene i primijenjene u drugim zemljama i prehrambenim sektorima. Smanjenje mogućnosti za prijevaru pomoći će u stvaranju pravednog, zdravog i ekološki prihvatljivog prehrambenog sustava, kako je predviđeno strategijom EU-a „Od polja do stola”.
- Alati razvijeni u sklopu projekta WATSON pomoći će nam da izgradimo dodatni sloj zaštite od prijevara povezanih s hranom koje mogu ozbiljno naštetiti i lancima opskrbe hranom i okolišu - rekao je Argyropoulos.
Istraživanja u ovom članku financira EU-ov program Obzor. Stavovi sugovornika ne odražavaju nužno stavove Europske komisije.
Autor Ali Jones
Ovaj je članak izvorno objavljen u časopisu Horizon, časopisu za istraživanje i inovacije EU-a.
Igre na sreću mogu izazvati ovisnost. 18+